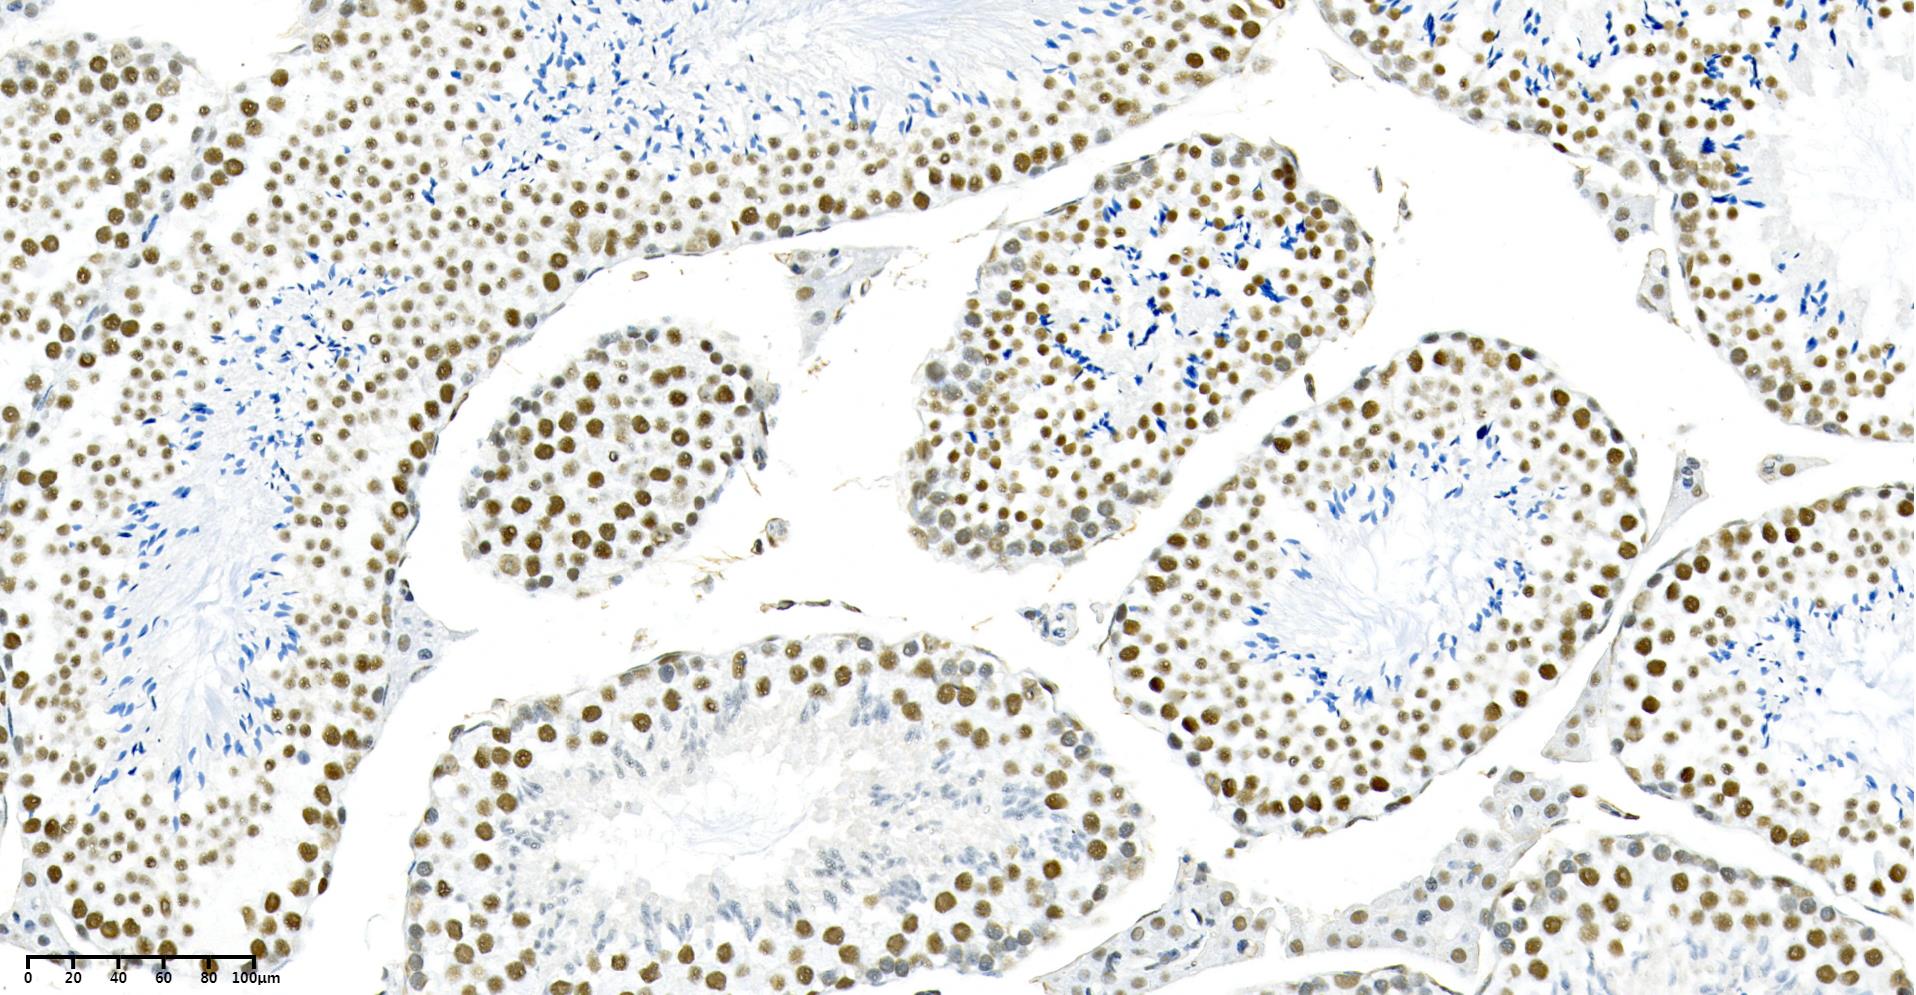

- 细胞类
- 生化试剂
- ELISA检测
-
抗体蛋白
二抗生物素标记 过氧化物酶(HRP)标记 胶体金试剂 FITC荧光标记 RBITC荧光标记 二抗免疫血清 其它荧光标记二抗 藻红蛋白(PE)荧光标记 胶体金(Gold)标记 SAlexa Fluor荧光系列 碱性磷酸酶(AP)标记 别藻蓝蛋白(APC)荧光标记 其它标记 PE标记二抗 DyLight标记二抗 AU标记二抗 Biotin标记二抗 AMCA标记二抗 Texas Red标记二抗 TRITC标记二抗 HRP标记二抗 未标记二抗 Cy标记二抗 AbBox Fluor标记二抗内参抗体 小分子抗体抗体标记试剂盒细菌抗体蛋白病毒包装试剂杂交瘤融合筛选WB、IHC、ELISA相关试剂细胞培养试剂病原微生物抗原抗体假病毒抗体校准品其他抗原抗体标记的标签抗体病理级IHC抗体重组蛋白
- 细胞培养
- 实验耗材
- 仪器设备
- 生化试剂盒
- 小分子试剂
- 基质胶
-
斑马鱼产品
订货时间:周一至周五
订货Q Q:79688691
订货邮件:79688691@qq.com
产品简介-
产品货号IM68904
-
别名N6-adenosine-methyltransferase 70 kDa subunit (MT-A70) (EC 2.1.1.62) (Methyltransferase-like protein 3);MTA70
-
产品名称METTL3 (1S11) Rabbit Monoclonal Antibody
-
类别抗体产品
-
基因名称METTL3
-
蛋白名称N6-adenosine-methyltransferase 70 kDa subunit (MT-A70) (EC 2.1.1.62) (Methyltransferase-like protein 3)
-
ClonalityMonoclonal
-
推荐应用WB,IHC-P,IF-P,IF-F,IF-ICC,IP,ELISA
-
反应种属Human,Mouse,Rat
-
存储缓冲液PBS, 50% glycerol, 0.05% Proclin 300, 0.05%BSA
-
Human Gene ID56339
-
Human Swissprot No.Q86U44
-
Mouse Gene ID56335
-
Mouse Swissprot No.Q8C3P7
-
稀释度IHC-P 1:200-400,WB 1:1000-5000,IF-P/IF-F/IF-ICC 1:200-1000,ELISA 1:5000-20000,IP 1:50-200
-
参考分子量70kDa
-
预测分子量64kDa
-
宿主Rabbit
-
同种型Monoclonal, rabbit, IgG, Kappa
-
功能The METTL3-METTL14 heterodimer forms a N6-methyltransferase complex that methylates adenosine residues at the N(6) position of some RNAs and regulates various processes such as the circadian clock, differentiation of embryonic and hematopoietic stem cells, cortical neurogenesis, response to DNA damage, differentiation of T-cells and primary miRNA processing . In the heterodimer formed with METTL14, METTL3 constitutes the catalytic core . N6-methyladenosine (m6A), which takes place at the 5'-[AG]GAC-3' consensus sites of some mRNAs, plays a role in mRNA stability, processing, translation efficiency and editing . M6A acts as a key regulator of mRNA stability: methylation is completed upon the release of mRNA into the nucleoplasm and promotes mRNA destabilization and degradation . In embryonic stem cells (ESCs), m6A methylation of mRNAs encoding key naive pluripotency-promoting transcripts results in transcript destabilization, promoting differentiation of ESCs (By similarity). M6A regulates the length of the circadian clock: acts as an early pace-setter in the circadian loop by putting mRNA production on a fast-track for facilitating nuclear processing, thereby providing an early point of control in setting the dynamics of the feedback loop (By similarity). M6A also regulates circadian regulation of hepatic lipid metabolism . M6A regulates spermatogonial differentiation and meiosis and is essential for male fertility and spermatogenesis (By similarity). Also required for oogenesis (By similarity). Involved in the response to DNA damage: in response to ultraviolet irradiation, METTL3 rapidly catalyzes the formation of m6A on poly(A) transcripts at DNA damage sites, leading to the recruitment of POLK to DNA damage sites . M6A is also required for T-cell homeostasis and differentiation: m6A methylation of transcripts of SOCS family members (SOCS1, SOCS3 and CISH) in naive T-cells promotes mRNA destabilization and degradation, promoting T-cell differentiation (By similarity). Inhibits the type I interferon response by mediating m6A methylation of IFNB . M6A also takes place in other RNA molecules, such as primary miRNA (pri-miRNAs) . Mediates m6A methylation of Xist RNA, thereby participating in random X inactivation: m6A methylation of Xist leads to target YTHDC1 reader on Xist and promote transcription repression activity of Xist . M6A also regulates cortical neurogenesis: m6A methylation of transcripts related to transcription factors, neural stem cells, the cell cycle and neuronal differentiation during brain development promotes their destabilization and decay, promoting differentiation of radial glial cells (By similarity). METTL3 mediates methylation of pri-miRNAs, marking them for recognition and processing by DGCR8 . Acts as a positive regulator of mRNA translation independently of the methyltransferase activity: promotes translation by interacting with the translation initiation machinery in the cytoplasm . Its overexpression in a number of cancer cells suggests that it may participate in cancer cell proliferation by promoting mRNA translation . During human coronorivus SARS-CoV-2 infection, adds m6A modifications in SARS-CoV-2 RNA leading to decreased DDX58/RIG-I binding and subsequently dampening the sensing and activation of innate immune responses .
-
纯化Protein A
储存与保存1.保存:-20℃
2.有效期:1年
注意事项1.我司生产的生化试剂如无特殊标注,基本为非无菌包装,若用于细胞实验,请提前做好预处理。需低温保存的产品,一旦配成溶液,请分装保存,避免反复冻融造成的产品失效。
2.本产品仅供科研使用。请勿用于医药、临床诊断或治疗,食品及化妆品等用途。请勿存放于普通住宅区。
3.为了您的安全和健康,请穿好实验服并佩戴一次性手套和口罩操作。
4.实验结果可由多种因素影响,相关处理只限于产品本身,不涉及其他赔偿。
备注:由于产品信息可能会有优化升级,请以实际收货标签信息为准。